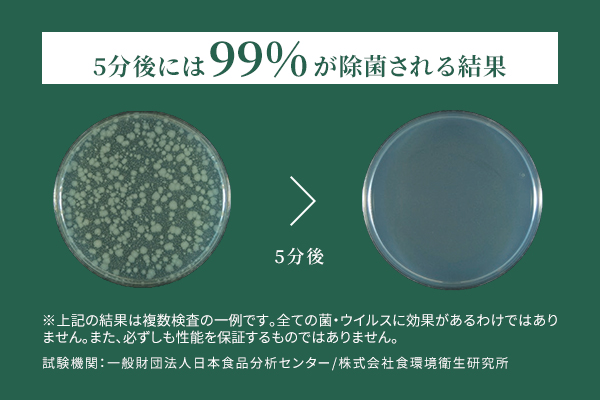

広がる、香りとくつろぎ
広がる、香りとくつろぎ
「能登ヒバ」の良さを生かした
エッセンシャルオイル&ウォーター

NOTOHIBAKARAってどんなモノ?
「能登ヒバ」から生まれた
天然成分100%の人に優しい蒸留水
【抗菌・除菌】【消臭・アロマ】【防虫】といった「能登ヒバ」の素晴らしい性質と効果を発揮するエッセンシャルオイル&ウォーター。
能登ヒバ蒸留水のみで作られているため天然成分100%で環境や人にも優しく、お子様やペットのいるご家庭でも安心してお使いいただけます。確かな除菌・消臭力で除菌・除ウイルス効果を期待できます。


ヒバは”ヒノキチオール”という天然成分を多く含み、シロアリや細菌を寄せ付けないという特性があります。湿気に強く、非常に腐りにくい優れた耐久性から、輪島漆器の木地や、金沢の小羽根などに使われ、外国ではカヌーやオール等にも使われています。
“ヒノキチオール”の優れた抗菌力や殺菌力により、「能登ヒバ」は、ヒノキや杉に比べても腐りにくく、丈夫で⾧持ちです。

-

- NOTOHIBAKARA
エッセンシャルオイル(天然精油)5ml 能登ヒバから生まれたエッセンシャルオイル - 能登ヒバを蒸留して作られた芳香性・揮発性の高い高品質なオイルです。ルームフレグランスやルームフレッシュナー等として自然の香りをお楽しみください。 BUY NOW
- NOTOHIBAKARA
-
- NOTOHIBAKARA
エッセンシャルウォーター 200ml 空間に広がる心地よい能登ヒバの香り - 除菌・除ウイルス・消臭成分を含み、リラックス効果のある能登ヒバの香りが広がることで心地よい環境を作ります。ヒバから抽出されたヒバ蒸留水のみで作られており、化学合成成分・アルコールを一切使用せず、100%の天然成分にこだわった製品です。除菌から空間の香り付けまで幅広いシーンでご使用いただけます。 BUY NOW

- NOTOHIBAKARA
-

- NOTOHIBAKARA
アロマディフューザセット - 能登ヒバから抽出されたヒバ蒸留水のみを使用したリフィルは、除菌・除ウイルス・消臭成分を含み、化学合成成分・アルコールを一切使用せず、100%の天然成分にこだわった製品です。お子様やペットのいるご家庭でもご使用していただけます。ディフューザーから広がる能登ヒバの優しい香りが心とからだを癒し、心地よい環境を作ります。 BUY NOW
- NOTOHIBAKARA
 抗菌・除菌5種の菌に対して抗菌・除菌作用
抗菌・除菌5種の菌に対して抗菌・除菌作用- 大腸菌、O-157、黄色ブドウ球菌、MRSA(院内感染菌)、化膿連鎖球菌をへの有効性が実験で確認されており、カビや雑菌の繁殖を防ぎます(ヒノキの数倍〜数百倍とも言われています)。
※日本食品分析センター調べ 性能試験はこちら

抗ウイルスウイルスに対する不活化効果
抗ウイルスウイルスに対する不活化効果- 2種のウイルス(インフルエンザウイルス、ネコカリシウイルス(ノロウイルス代替))に対する不活化効果試験済みです。3時間後には98%の不活化が認められました。
※食品環境衛生所調べ 性能試験はこちら
 消臭・アロマ嫌な匂いを消臭、
消臭・アロマ嫌な匂いを消臭、
爽快感のある香り- アンモニアに対する強い消臭効果、蚊を寄せ付けない忌避効果、アロマ効果があります。アンモニアに対しては10分で74%を消臭する効果が得られました。ヒバは爽快感のある森の香りを放ち、室内でも心とからだを癒やしリラックス効果が得られます。 性能試験はこちら


 安全性天然成分100%だから、
安全性天然成分100%だから、
環境にも人にも優しい- 天然成分100%のヒバ蒸留水のみで作られているため、環境に優しいだけでなく、人にも優しい商品です。急性経口毒試験・皮膚一次刺激性試験にて安全性確認済みなので、お子様やペットのいるご家庭でも安心してお使いいただけます。 性能試験はこちら
加賀木材の取り組み
山への恩返しプロジェクト
はるか昔から、山に抱かれてきた人の暮らし。
木の実や動物を糧とし、道具を作り、火を起こし、家を建て、
家族が、文明社会が生まれました。
豊かな山はまた、豊かな海を育み、循環する暮らしにつながっています。
山を守ることは環境を、未来を守ること。
江戸時代から北前船で木を扱ってきた私たち加賀木材の次のアクション。
それが「山への恩返しプロジェクト」です。
人と自然をつなぎ、その暮らしを未来につなぐ。
金沢の、石川の未来を地域の方と
共に豊かにするための活動を展開しています。
木の良さを
身近に感じられる
様々な事業
-

- NOTOHIBAKARAnoie
- NOTOHIBAKARAnoieでは住宅、店舗、リフォームなどの設計施工を行っています。「能登ヒバ」を活用し皆様の暮らしに健康と安心そして安らぎを添えるお手伝いをしています。加賀木材が持つ創業120年のノウハウをもとに適材適所に「木」をはじめ厳選素材、妥協のない構法やデザインで本質的価値のある空間を提案します。
-

- NOTOHIBAKARAベーカリー
- 「能登ヒバ」にこだわった“豊かな空間で本当に美味しいものを”という思いからベーカリーカフェです。
暮らしに欠かすことのできない「食」と「生活空間」から、ライフスタイルを豊かにすることを目指しています。かつて、北前船や輪島塗などで親しまれきた「能登ヒバ」を店内のいたるところに使い、まるで明るい森の中のような気持ちいい空間を再現しています。
-

- Wood Style Cafe
- ウッドスタイルカフェは「木のぬくもりがあふれる癒しの空間」をコンセプトに生まれました。
能登産のヒバ材をふんだんに使った木の香りがあふれる店内にはキッズスぺースも完備。地域の子育てを応援することを目的に作られた、小さなお子様連れでもゆっくりできるカフェです。
-

- Wood Style Beauty
- 女性をあらゆるストレスから解放し、美と健康を追求することがWood Style Beauty(ウッドスタイルビューティー)のコンセプト。酵素浴、整体に加えて、オーガニックオイルによるリンパマッサージを組み合わせることで、全身の細胞が活性化し、抵抗力や自然治癒力が向上します。
-

- 能登ヒバから生まれた 木のアロマ枕
- 能登ヒバチップとそば殻を使った枕です。ほのかに香るヒバの香りは気分を落ち着かせ安眠を誘うリラックス効果があります。思わず深呼吸したくなるような能登ヒバの香りで睡眠環境をサポートします
<除菌&除ウイルススプレー付き>
能登ヒバから独自製法によって抽出した天然成分100%の除菌・除ウイルス・消臭スプレーをセットにしました。毎日、枕にスプレーすることで除菌・消臭の効果が期待できます。
BUY NOW
-

- NOTOHIBAKARA 森の積み木セット
- お子さんやお孫さんのお誕生祝いにぴったりな、積み木のセット商品です。能登ヒバ材には抗カビ・抗菌作用があり、心地よい香りを感じながら、安心してお子様と一緒に楽しんでいただけます。また、木の温もりも感じられるため、贈り物としてもおすすめです。 能登ヒバのエッセンシャルウォーター(100ml)もセットにしました。 BUY NOW
-

- NOTOHIBAKARA
シューキーパー&靴用スプレーセット - 抗菌・消臭に優れた能登ヒバを原材料に使用し、従来のシューキーパーの型崩れ防止の機能に除菌・消臭の効果も付加。
また、能登ヒバのオイル及び数種のオイルをブレンドした除菌・消臭・防カビ効果を高めた靴用スプレーをセットにしました。
BUY NOW
- NOTOHIBAKARA
-

- NOTOHIBAKARA 動物パズル
- 素材にふれて感じる能登ヒバのぬくもり 能登ヒバから生まれた11種類の動物パズル。
能登ヒバには抗カビ・抗菌作用があり、心地よい香りを感じながら、安心してお子様と一緒に楽しんでいただけます。また、木の温もりも感じられるため、贈り物としてもおすすめです。
BUY NOW
-

- NOTOHIBAKARA アロマウッドボール
- 木の温かみを肌で感じられる手のひらサイズのグッズです。
不純物が含まれていない自然の木そのものなので、まるで森林にいるかのような心地よい香りが漂ってきます。マッサージボールとしてデスクワークの合間のリフレッシュに、湯船に浮かべればよい香りに包まれたバスタイムを過ごせます。
抗菌力も優れているので、木育としてお子様へのギフトにもおすすめです。
BUY NOW
-

- NOTOHIBAKARA
除菌・消臭スプレー&マスクセット(2枚) - スプレーでシュッとするだけ簡単お手入れ。
天然成分100%のスプレーが、自然由来の確かな除菌・除ウイルス・消臭作用で、快適なマスク習慣に。※マスクは感染(侵入)を完全に防ぐものではありません。
BUY NOW
- NOTOHIBAKARA
-

- NOTOHIBAKARA ウッドクッション
- 能登ヒバの持つ保存・防カビ・抗菌効果をそのままに大切なものを外部の刺激から守ってくれます。まるで森林にいるかのような心地よい香りを感じられ、大切なプレゼントから、オーガニック商品の梱包のための緩衝材としてなど。幅広い用途でお使いいただけます。 BUY NOW



